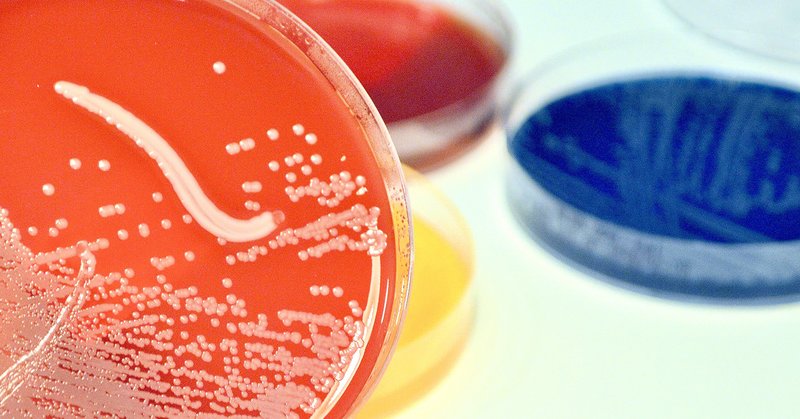
Tweet card summary image

Stanford Office of Technology Licensing (OTL)
@StanfordOTL
Followers
2K
Following
208
Media
203
Statuses
1K
OTL is responsible for licensing state-of-the-art Stanford University technologies. Interested in an invention? DM or email us at [email protected]!
Redwood City, CA
Joined April 2012
Meet with @StanfordOTL at TechConnect! Jon Gortat, David Mallin, and Evan Elder will be representing Stanford OTL at this year’s TechConnect in Austin, TX from June 9-11. 💡Preview Stanford OTL Technologies before your meeting with us: https://t.co/tLekdk8hrj
0
0
0
🎉@parkerici celebrates @StanfordOTL inventor Crystal Mackall, whose visionary work at the frontiers of immunotherapy has earned three prestigious recognitions! 🔬View available technologies from Crystal Mackall: https://t.co/tP4jKTeqTT
Pediatric oncology has seen decades of stagnation—a “market failure,” as Crystal Mackall, MD, describes it. PICI proudly celebrates Dr. Mackall, Director of the PICI Center at @StanfordMed, whose pioneering work in T-cell therapy is reshaping what’s possible for children with
0
0
2
🗞️Read Recently Released Publication “DNA binding and mitotic phosphorylation protect polyglutamine proteins from assembly formation:”
cell.com
DNA binding and phosphorylation protect FOXP2, a transcription factor with the longest polyQ track in the proteome, from aggregation during interphase and mitosis. Harnessing these native solubilit...
0
2
3
Digital tool gives kids with ADHD real-time feedback on their brains 🗞️ https://t.co/NhEWNrdnUF 💡Licensing details available soon
news.stanford.edu
In a recent study of a technique to help kids with ADHD strengthen their working memory, about half of participants showed improvements in their symptoms. The concept holds promise for other neurop...
0
0
1
Join the Stanford OTL Team! Now #Hiring a Senior Associate Director for Licensing and Strategic Alliances. 🖋️Full job summary:
careersearch.stanford.edu
The Office of Technology Licensing (OTL) at Stanford University is seeking a highly qualified and dynamic professional to join our team as the Senior....
0
0
2
🏃🏽♀️Related technology, “Real-time electromyography feedback to change relative muscle activity” from Scott Delp and Scott Uhlrich available for licensing: https://t.co/b4QlxgntVo
0
0
0
⚾️“Athletes and scientists are constantly seeking to improve and push boundaries, whether on the field or in the lab. By joining forces, we are discovering new insights in both the world of sports and science.” https://t.co/M7VlY79K4Y
news.stanford.edu
Wu Tsai Human Performance Alliance scientists and Cardinal athletes are working together to apply cutting-edge research to real-world sports performance – yielding insights that advance both fields.
1
0
0
🍛Leveraging AI, researchers have identified a naturally occurring molecule that can suppress appetite and facilitate weight loss in mice and pigs: https://t.co/JHb7kd3bod
news.stanford.edu
Leveraging AI, researchers have identified a naturally occurring molecule that can suppress appetite and facilitate weight loss in mice and pigs.
0
0
0
📣At the WISE Dialogue 2024 (March 12–13), @VanorioTiziana will present cement technology Phlego—a low-carbon, white cement designed for seamless integration into existing manufacturing processes! 🛣️Read More:
0
0
0
“This opens an entirely new avenue for treating brain aging and related diseases.” @sophmshi
https://t.co/zNyyYoscxa
@CarolynBertozzi @wysscoray 🧠Available for Licensing
news.stanford.edu
New findings about the sugary armor on the brain’s frontline cells could shed light on cognitive decline and diseases like Alzheimer’s – and open new avenues for treatment.
0
0
1
#AUTM50 👶3.4 Enhancing Pediatric Access to Cell & Gene Therapies — How TTOs Can Help, Crystal Mackall & Sunita Rajdev 🌊3.4 Making Waves: Amplifying Impact as Operations Professionals in TTOs, Stella Colic 🔐3.4 National Security & TTOs: Practical Guidance ,Jonathan Gortat
0
0
0
Evo 2 can predict form and function of proteins in the DNA of all domains of life, identify molecules useful for bioengineering and medicine, and run experiments in a fraction of the time it would take a traditional lab. “It is really good at discovery.” https://t.co/seTDjXJYGu
0
1
1
📢Attention Researchers: 2025 IMA Small Molecule Therapeutics Request for Proposals (RFP) from Stanford Innovative Medicines Accelerator (IMA)! ⏰Deadline: All applications must be received by 5 PM PDT on Friday, March 28th, 2025. Proposal Instructions:
ima.stanford.edu
The Stanford Innovative Medicines Accelerator (IMA) is accepting proposals for projects that address two major challenges in small molecule drug discovery and development: adaptation of laboratory-...
0
0
4
FDA clears sepsis test from Stanford licensee, @Inflammatix_Inc , that significantly reduces life-or-death diagnosis time! @purveshkhatri 🗞️ https://t.co/WNuBCRYXkB
news.stanford.edu
Purvesh Khatri, whose lab at Stanford Medicine developed the test, discusses a breakthrough that could be transformative for millions of patients each year.
0
2
7
🖨️Prints and the Revolution: How researchers are wielding a tool to repair our 3D bodies From Stanford Magazine: https://t.co/qQ4SuYgTnw
@Joseph_DeSimone @ReneeRZhao
stanfordmag.org
How researchers are wielding a tool to repair our 3D bodies.
0
1
2
✈️See Stephen W. Tsai’s technologies available for licensing: https://t.co/srsfcc0WlH 🗞️Read Stanford OTL’s profile of A Revolution in Composites: Professor Stephen Tsai's Vision for a Lighter Future:
otl.stanford.edu
0
0
0
🎉Congratulations to Stephen W. Tsai to Receive the 2025 Daniel Guggenheim Medal for Revolutionizing Composite Materials Technology for Aerospace! https://t.co/sNarliQDlc
aiaa.org
Stephen W. Tsai has been awarded the 2025 Daniel Guggenheim Medal for his series of pioneering innovations revolutionizing design and simplifying manufacturing processes of composites, shaping...
1
0
1
The @CdcmStanford 9th Annual Symposium is less than a month away - register today! Annual symposium revolving around cell & gene therapy field with speakers from academia, not-for-profits, the federal government, & industry.
Join us on February 26, 2025 for the CDCM's 9th Annual Symposium! You don't want to miss this one-day conference on Stanford Campus! Please register here: https://t.co/LS1cV9Fibv
#cdcm #gmp #clinicaltrials #stemcell #genetherapy #stanford #celltherapy
0
0
2
“Advances like these require everyone working together,” says director Crystal Mackall. “It’s not just one brilliant scientist toiling over a laboratory bench.” https://t.co/KupsLTcDBK Immuno-oncology: Cell Therapy technologies available for licensing:
stanmed.stanford.edu
Stanford Medicine’s Center for Cancer Cell Therapy brings together diverse experts to devise cell-based treatments for deadly cancers.
0
0
1